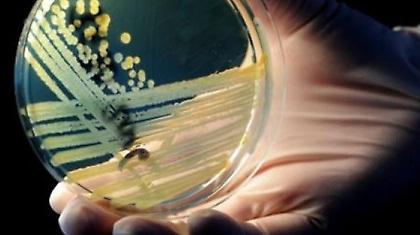
Στους 19 οι νεκροί από το βακτήριο E.coli

Επικαιρότητα
Ενημερωθείτε για οτιδήποτε νεότερο στον κόσμο του/της Επικαιρότητα, με την εγκυρότητα και αμεσότητα της δημοσιογραφικής ομάδας του bwinΣΠΟΡ FM 94.6. Ζήστε τον παλμό της επικαιρότητας μέσα από άρθρα, συνεντεύξεις, highlights και πολλά άλλα αποκλειστικά αφιερώματα!